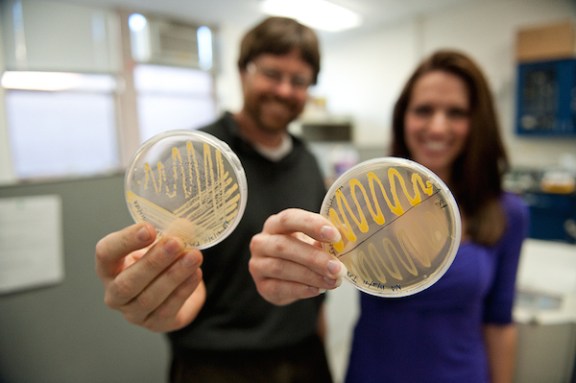

Recycling the dead
The decay of dead things is simply nature’s way of mining old materials for new uses
Moss covers a dead tree in Pennsylvania’s Weiser State Forest. The decomposition that follows the death of every organism sets the stage for new life. It’s nature’s way of recycling.
Nicholas A. Tonelli/Flickr
Share this:
- Share via email (Opens in new window) Email
- Share on Facebook (Opens in new window) Facebook
- Share on X (Opens in new window) X
- Share on Pinterest (Opens in new window) Pinterest
- Share on Reddit (Opens in new window) Reddit
- Share to Google Classroom (Opens in new window) Google Classroom
- Print (Opens in new window) Print
Eventually, all living things die. And except in very rare cases, all of those dead things will rot. But that’s not the end of it. What rots will wind up becoming part of something else.
This is how nature recycles. Just as death marks the end of an old life, the decay and decomposition that soon follow provide material for new life.
“Decomposition breaks apart dead bodies,” explains Anne Pringle. She’s a biologist at Harvard University in Cambridge, Mass.
When any organism dies, fungi and bacteria get to work breaking it down. Put another way, they decompose things. (It’s the mirror image of composing, where something is created.) Some decomposers live in leaves or hang out in the guts of dead animals. These fungi and bacteria act like built-in destructors.

Yes, rotting can be yucky and disgusting. Still, it is vitally important. Decomposition aids farmers, preserves forest health and even helps make biofuels. That is why so many scientists are interested in decay, including how climate change and pollution may affect it.
Welcome to the world of rot.
Why we need rot
Decomposition isn’t just the end of everything. It’s also the start. Without decay, none of us would exist.
“Life would end without rot,” observes Knute Nadelhoffer. He’s an ecologist at the University of Michigan in Ann Arbor. “Decomposition releases the chemicals that are critical for life.” Decomposers mine them from the dead so that these recycled materials can feed the living.

“The carbon cycle really is about life and death,” observes Melanie Mayes. She’s a geologist and soils scientist at Oak Ridge National Laboratory in Tennessee.
The carbon cycle starts with plants. In the presence of sunlight, green plants combine carbon dioxide from the air with water. This process, called photosynthesis, creates the simple sugar glucose. It’s made of nothing more than the carbon, oxygen and hydrogen in those starting materials.
Plants use glucose and other sugars to grow and fuel all of their activities, from breathing and growth to reproduction. When plants die, carbon and other nutrients stay in their fibers. Stems, roots, wood, bark and leaves all contain these fibers.
The ‘fabric’ of plants
“Think of a leaf like a piece of cloth,” says Jeff Blanchard. This biologist works at the University of Massachusetts — or UMass — in Amherst. Cloth is woven with different threads, and each thread is made of fibers spun together.

When a plant dies, microbes and even larger fungi break down these fibers. They do so by releasing enzymes. Enzymes are molecules made by living things that speed up chemical reactions. Here, different enzymes help snip apart chemical bonds that hold together the fibers’ molecules. Snipping those bonds releases nutrients, including glucose.
“Cellulose is essentially glucose rings that are attached to one another,” explains Mayes. During decomposition, enzymes attach to the cellulose and break the bond between two glucose molecules. “The isolated glucose molecule can then be taken up as food,” she explains.
The decomposer organism can use that sugar for growth, reproduction and other activities. Along the way, it releases carbon dioxide back into the air as waste. That sends carbon back for reuse as part of that never-ending carbon cycle.
But carbon is far from the only thing that gets recycled this way. Rot also releases nitrogen, phosphorus and about two dozen other nutrients. Living things need these to grow and prosper.

The DIRT on decay
The world would be very different if the rates at which things decay were to change. To find out how different, Nadelhoffer and other scientists are probing rot in forests around the world. Study sites include the Michigan Biological Station in Ann Arbor and the Harvard Forest near Petersham, Mass.
They call one series of these experiments DIRT. It stands for Detritus Input and Removal Treatments. Detritus is debris. In a forest, it includes the leaves that fall and litter the ground. Scientists on the DIRT team add or remove leaf litter from particular parts of a forest.
“Every year in fall, we take all the litter off an experimental plot and we put it on another plot,” explains Nadelhoffer. The researchers then measure what happens to each plot.
Over time, leaf-starved forest soils undergo a range of changes. Scientists refer to the carbon-rich materials released from once-living organisms as organic matter. Soils deprived of leaf litter have less organic matter. That’s because there are no more decomposing leaves to supply carbon, nitrogen, phosphorus and other nutrients. The soils deprived of leaf litter also do a poorer job of releasing nutrients back to plants. The types of microbes present and the numbers of each also change.
Meanwhile, forest soils given bonus leaf litter become more fertile. Some farmers use the same idea. Tilling means plowing. In no-till farming, growers just leave plant stalks and other debris on their fields, instead of plowing them under after a crop’s harvest. Since plowing can release some of the soil’s carbon to the air, no-till can keep the soil more fertile, or carbon-rich.

As a result, farmers don’t have to plow or to fertilize as much. That can reduce soil erosion and runoff. Less runoff means soils will lose fewer nutrients. And that means those nutrients also won’t go on to pollute lakes, streams and rivers.
Heating up
A much larger experiment is going on worldwide. Scientists refer to it as climate change. By 2100, average global temperatures likely will rise between 2° and 5° Celsius (4° and 9° Fahrenheit). Much of that increase comes from people burning oil, coal and other fossil fuels. That burning adds carbon dioxide and other gases to the air. Like a greenhouse window, those gases trap heat near Earth’s surface so that it doesn’t escape into space.
How Earth’s rising fever will affect the speed at which things rot isn’t clear. It comes down to something called feedbacks. Feedbacks are outside changes to a process, such as global warming. Feedbacks can either increase or decrease the pace at which some change occurs.
For example, higher temperatures can lead to more decomposition. That’s because the extra warmth is “putting more energy into the system,” says Mayes at Oak Ridge. In general, she explains, “An increase in temperature will tend to cause reactions to happen more quickly.”

And if climate change speeds rot, it will also speed how quickly more carbon dioxide enters the atmosphere. “More carbon dioxide means more warming,” notes Serita Frey. She is a biologist at the University of New Hampshire in Durham. And now a feedback cycle develops. “More warming leads to more carbon dioxide, which leads to more warming, and so on.”
In fact, the situation is more complicated, Mayes cautions. “As temperature increases, microbes themselves tend to get less efficient,” she says. “They have to work harder to do the same thing.” Think of how yard work takes more effort on a hot, humid afternoon.
To learn more, Mayes, Gangsheng Wang and other soil researchers at Oak Ridge National Laboratory created a computer program to model how global warming and other aspects of climate change would affect the speed at which dead things break down. The model’s virtual world lets them test how different scenarios might lead to different rates of rot in the real world.
They published a follow-up study in the February 2014 PLOS ONE. This analysis accounted for those times of the year when microbes are dormant, or inactive. And here, the model didn’t predict that feedbacks would boost carbon dioxide emissions as other models had. It appears that after a few years, microbes may simply adjust to higher temperatures, Mayes explains. It’s also possible that other microbes might take over. Simply put: Predicting future consequences is difficult.
Exaggerating climate effects in the field
Outdoor experiments provide more insights. In the Harvard Forest, scientists aren’t waiting for the world to grow any warmer. For more than two decades now, experts there have used underground electric coils to artificially warm certain soil plots.
“Warming is increasing the microbial activity in the forest, resulting in more carbon dioxide going back up into the atmosphere,” says Blanchard, the UMass biologist. More carbon going into the air means less remains in the topsoil. And that’s where plants grow. “That organic layer on the top has decreased by about a third during the last 25 years of our warming experiment.”
The impacts of this drop in carbon on soil fertilty could be huge, says Blanchard. “It’s going to change the competition among plants.” Those that need more carbon may get edged out by those that don’t.

Burning fossil fuels isn’t just about carbon dioxide and warming, however. It also adds nitrogen compounds to the air. Eventually, the nitrogen falls back to Earth in rain, snow or dust.
Nitrogen is part of many fertilizers. But just as too much ice cream can make you sick, too much fertilizer isn’t good. That is especially true in many areas near big cities and industrial areas (such as where the Harvard Forest grows).
For some of those areas, 10 to 1,000 times as much nitrogen gets added to the soil each year compared to back in the 1750s. That’s when the Industrial Revolution started, launching the heavy use of fossil fuels that continues today. The result: Soil levels of nitrogen continue to grow.
“Soil organisms are not adapted for those conditions,” says Frey at the University of New Hampshire. “For reasons that we’re still trying to understand, [too much nitrogen] slows the ability of soil microbes to decompose organic matter.”
Higher nitrogen levels seem to reduce the ability of microbes to make the enzymes needed to break down dead tissues. As a result, plant litter on the forest floor will get recycled more slowly. That can affect the overall health of the area’s living trees and other plants.
“If those nutrients are still locked up in that material, then those nutrients are not available for the plants to take up,” says Frey. Pine trees in one test area of the Harvard Forest actually died from too much added nitrogen. “That has to do a lot with what was happening with the soil organisms.”
Pringle, at Harvard, agrees. Too much nitrogen slows decomposition in the short term, she says. “Whether that’s true on longer time scales is not clear,” she adds. Another open question: How will fungal communities change? In many areas, fungi break down most of the lignin in the woody parts of plants.
Fuel for thought
The science of rot matters as much for transportation as it does for trees. In fact, rot is key to better biofuels. Today, the big biofuel is ethanol, also known as grain alcohol. Ethanol is generally made from sugars derived from corn, cane sugar and other plants.

Rot is nature’s way of breaking down woody fibers to make glucose. That’s why scientists and engineers want to tap into that process. It could help them make biofuels less expensively. And they want to use far more than corn stalks as their plant sources. They also want to streamline the process to make their biofuels.
“If you want to make fuel from plant material, it has to be really efficient and cheap,” explains Kristen DeAngelis. She’s a biologist at UMass Amherst. Those goals have led scientists on a hunt for bacteria that are up to the task of breaking down plant material quickly and reliably.
One promising candidate is Clostridium phytofermentans (Claw-STRIH-dee-um FY-toh-fur-MEN-tanz). Scientists discovered this bacterium living near the Quabbin Reservoir, east of Amherst, Mass. In a one-step process, this microbe can break down hemicellulose and cellulose into ethanol. Blanchard and others at UMass Amherst recently found ways to speed the bacterium’s growth. That would also speed its ability to break down plant materials. Their findings appeared in the January 2014 PLOS ONE.
Meanwhile, with funds from the U.S. Department of Energy, DeAngelis and other scientists have been hunting for lignin-busting bacteria. Breaking down lignin could open up the use of woodier plants for biofuels. It also could let factories turn other types of plants into biofuels, while producing fewer wastes.
Fungi generally decompose lignin in temperate forests, such as those throughout most of the United States. However, those fungi wouldn’t work well in biofuel factories. Growing fungi on an industrial scale is just too expensive and difficult.
Rot and you
Decomposition doesn’t happen only in forests, farms and factories. Decomposition happens all around us — and inside us. For example, scientists are continuing to learn more about the crucial role played by gut microbes in digesting the food we eat.
“There’s still a lot of discovery that needs to be done,” says DeAngelis. “There are so many microbes that do all kinds of crazy things.”
You can experiment with rotten science too. “Start by adding kitchen and yard waste to a backyard compost pile,” suggests Nadelhoffer. In just a few months, decomposition will change that dead plant material to fertile humus. You can then spread it on your lawn or garden to promote new growth.
Hooray for decay!
